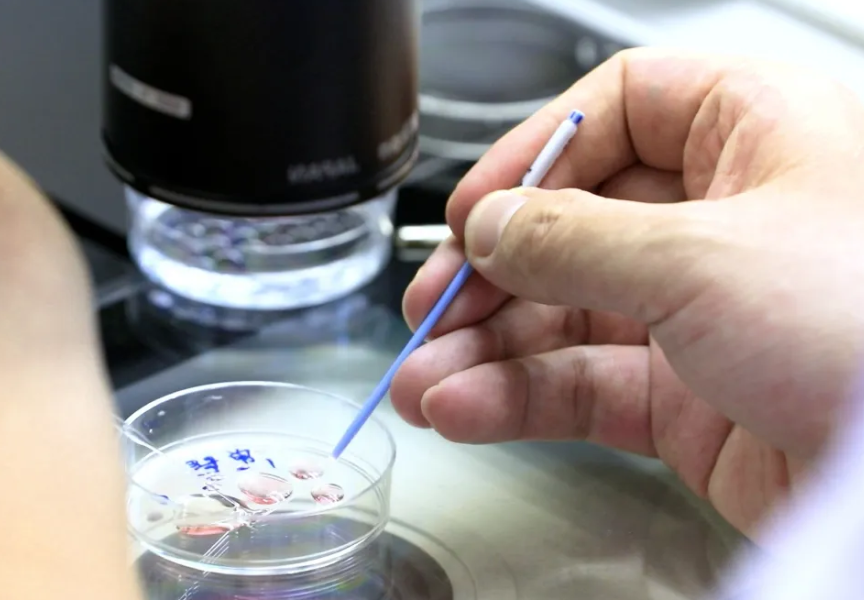

在近年来逐渐被广大夫妇接受和采用。然而由于一些误解和信息不对称,很多人认为三甲医院的试管冷冻费用会非常昂贵,但事实上并非如此,三甲医院的试管冷冻费用并没有想象中那么贵。
试管技术是辅助生殖技术中最常见也是最有效的方法之一。通过体外授精、胚胎培养和移植等步骤,可以帮助无法自然怀孕的夫妇实现生育梦想。虽然整个过程需要耗费一定的时间和金钱,但是相比于其他治疗方法,试管技术在成功率上有明显优势。
三甲医院试管冷冻费用
三甲医院作为国内最高级别的医疗机构,设备先进、专家团队强大,因此很多人认为其试管冷冻费用会非常高昂。然而实际情况并非如此。根据市场调查显示,在三甲医院进行试管冷冻的费用相对较低,并且价格透明,不会存在额外的隐性消费。
试管成功日记分享

三甲医院试管冷冻费用详解
为了让大家更加了解三甲医院的试管费用情况,下面是一个具体的:

尽管三甲医院的试管冷冻费用可能会有一定的花费,但相比于其他治疗方法和私立医院来说,并没有想象中那么贵。而且,选择正规的三甲医院进行试管操作能够获得更好的治疗效果和服务。希望通过本文能够消除大家对于试管费用高昂的误解,让更多需要帮助的夫妇能够实现生育梦想。








